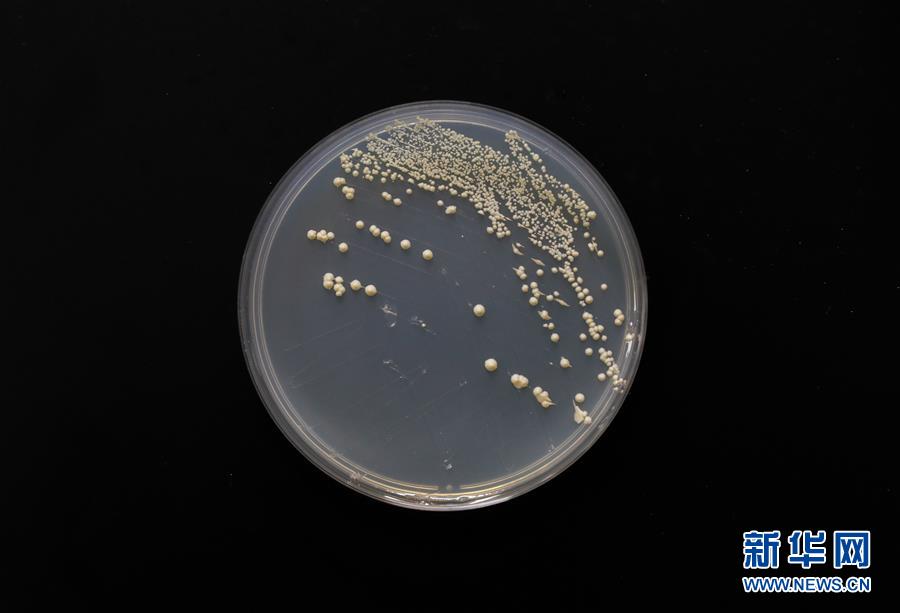
（科技）（4）中國&ldquo;創造&rdquo;世界首例單條染色體真核細胞

覃重軍團(tuán)隊及學(xué)生在中科院分子植物卓越中心/植生生態(tài)所合成生物學(xué)重點實驗室內(nèi)(7月31日攝)。
新華社上海8月2日電(記者張泉、王琳琳)中科院研究團(tuán)隊在國際上首次人工創(chuàng)建了單條染色體的真核細(xì)胞,是繼原核細(xì)菌“人造生命”之后的一個重大突破。北京時間8月2日,該成果在國際知名學(xué)術(shù)期刊《自然》在線發(fā)表。
歷經(jīng)4年,通過15輪染色體融合,中科院分子植物卓越中心/植生生態(tài)所覃重軍研究團(tuán)隊與合作者采用工程化精準(zhǔn)設(shè)計方法,成功將天然釀酒酵母單倍體細(xì)胞的16條染色體融合為1條,染色體“16合1”后的釀酒酵母菌株被命名為SY14。
經(jīng)鑒定,染色體三維結(jié)構(gòu)發(fā)生巨大變化的SY14酵母具有正常的細(xì)胞功能,除通過減數(shù)分裂有性繁殖后代減少外,SY14酵母表現(xiàn)出與野生型幾乎相同的轉(zhuǎn)錄組和表型譜。從而顛覆了染色體三維結(jié)構(gòu)決定基因時空表達(dá)的傳統(tǒng)觀念。

8月2日,中科院分子植物卓越中心/植生生態(tài)所研究員覃重軍在發(fā)布會上解讀研究成果。
此外,單條染色體真核細(xì)胞的“誕生”,突破了人們對于真核生物和原核生物界限的傳統(tǒng)認(rèn)知。
生物學(xué)教科書中將自然界存在的生命體分為具有被核膜包裹染色體細(xì)胞核的真核生物和染色體裸露無核膜包裹的原核生物,真核生物通常含有多條線型結(jié)構(gòu)的染色體,而原核生物通常含有一條環(huán)型結(jié)構(gòu)的染色體。
專家表示,該成果表明,天然復(fù)雜的生命體系可以通過人工干預(yù)變簡約,甚至可以人工“創(chuàng)造”自然界不存在的生命。
?
在中科院分子植物卓越中心/植生生態(tài)所內(nèi),覃重軍團(tuán)隊成員在電子顯微鏡前觀察單條染色體真核細(xì)胞形態(tài)(7月31日攝)。
覃重軍表示,該研究對于提升疾病防治水平具有重要意義。
釀酒酵母三分之一基因與人類基因同源。人類的過早衰老與染色體的端粒長度直接相關(guān),端粒的縮短還與許多疾病相關(guān)。與天然酵母的32個端粒相比,SY14酵母的單條線型染色體僅有2個端粒,為研究人類端粒功能及細(xì)胞衰老提供了很好的模型。
在中科院分子植物卓越中心/植生生態(tài)所合成生物學(xué)重點實驗室內(nèi)拍攝的單條染色體真核酵母(7月31日攝)。
自然科研機(jī)構(gòu)中國區(qū)總監(jiān)保羅·埃文斯表示,這些酵母菌株也可成為研究染色體生物學(xué)基本概念的強(qiáng)大資源,包括染色體的復(fù)制、重組和分離等,這些都是生物學(xué)領(lǐng)域長期以來十分重要的主題。
-
大數(shù)據(jù)"坑熟客",技術(shù)之罪需規(guī)則規(guī)避
2018-03-02 08:58:39
-
高質(zhì)量發(fā)展,怎么消除“游離感”?
2018-03-02 08:58:39
-
學(xué)校只剩一名學(xué)生,她卻堅守了18年
2018-03-01 14:40:53
-
有重大變動!騎共享單車的一定要注意了
2018-03-01 14:40:53
-
2018年,樓市會有哪些新變化?
2018-03-01 09:01:20
?